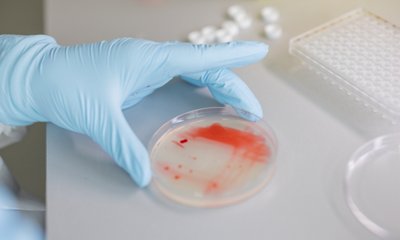
Infectious Diseases

Research and Development
bioMérieux’s R&D draws on more than a century of expertise in infectious disease management and a unique mastery of the three core technologies required for developing in vitro diagnostics. We invest 12-13% of our sales in R&D, the highest percentage of any other IVD company.
Inspiration comes not only from scientists and engineers, but also from envisioning the future with our customers and partners. Their input guides us from inspiration and invention to innovation, making sure that the creative idea becomes the right product for our customers.
Facts & Figures
- 900 people dedicated to R&D
- 13 R&D sites across the globe
- 3 main technologies
- growth-based microbiology (for which bioMérieux is the industry’s world leader),
- immunoassay systems,
- molecular-based technologies.
CLINICAL DIAGNOSTICS R&D FOCUS
A major focus of bioMérieux’s R&D is reducing the time to results to help clinicians choose the right treatment for their patients faster.
- Infectious disease management: bioMérieux’s primary development goal is to improve patients’ health by delivering results rapidly (rapid microbiology) and with greater automation. Furthermore, we are continuously expanding our product portfolio with high medical value parameters.
- Oncology: bioMerieux's core strategic focus is the development of high value prognostic and predictive tests to help project the likely course of disease and its response to treatment. The company is also developing early detection tests and is well positioned to exploit the growing evidence of links between infectious agents and cancers.
- Cardiovascular diseases: bioMérieux is developing high medical value assays in the cardiovascular field. Many of them will be run on our widely installed VIDAS platforms (26,000 worldwide), a unique platform that readily integrates technological advances and is well adapted for making rapid medical decisions at the patient’s point of care.
INDUSTRIAL APPLICATIONS R&D FOCUS
Agri-food, biopharmaceutical and cosmetic industries depend on the timely detection of contaminants such as bacteria, yeast and mold. Microbiological quality is tested from raw materials to the finished product, including the manufacturing environment.
- Food: To detect, identify and enumerate microorganisms, the testing methods we develop must overcome complex matrices for different types of food, which make it difficult to get the target organisms out of the sample and into the test device. Other challenges include competing microbial flora as well as preservatives and additives, which can interfere with the analysis. bioMérieux brings innovation to sample preparation by developing new solutions, and seeks out cutting-edge collaborations and licensing agreements.
- Biopharmaceutical industry: Our focus is to achieve complete traceability and data transfer, to reduce labor-intensive steps, and to obtain multiple pathogen information in a single test.